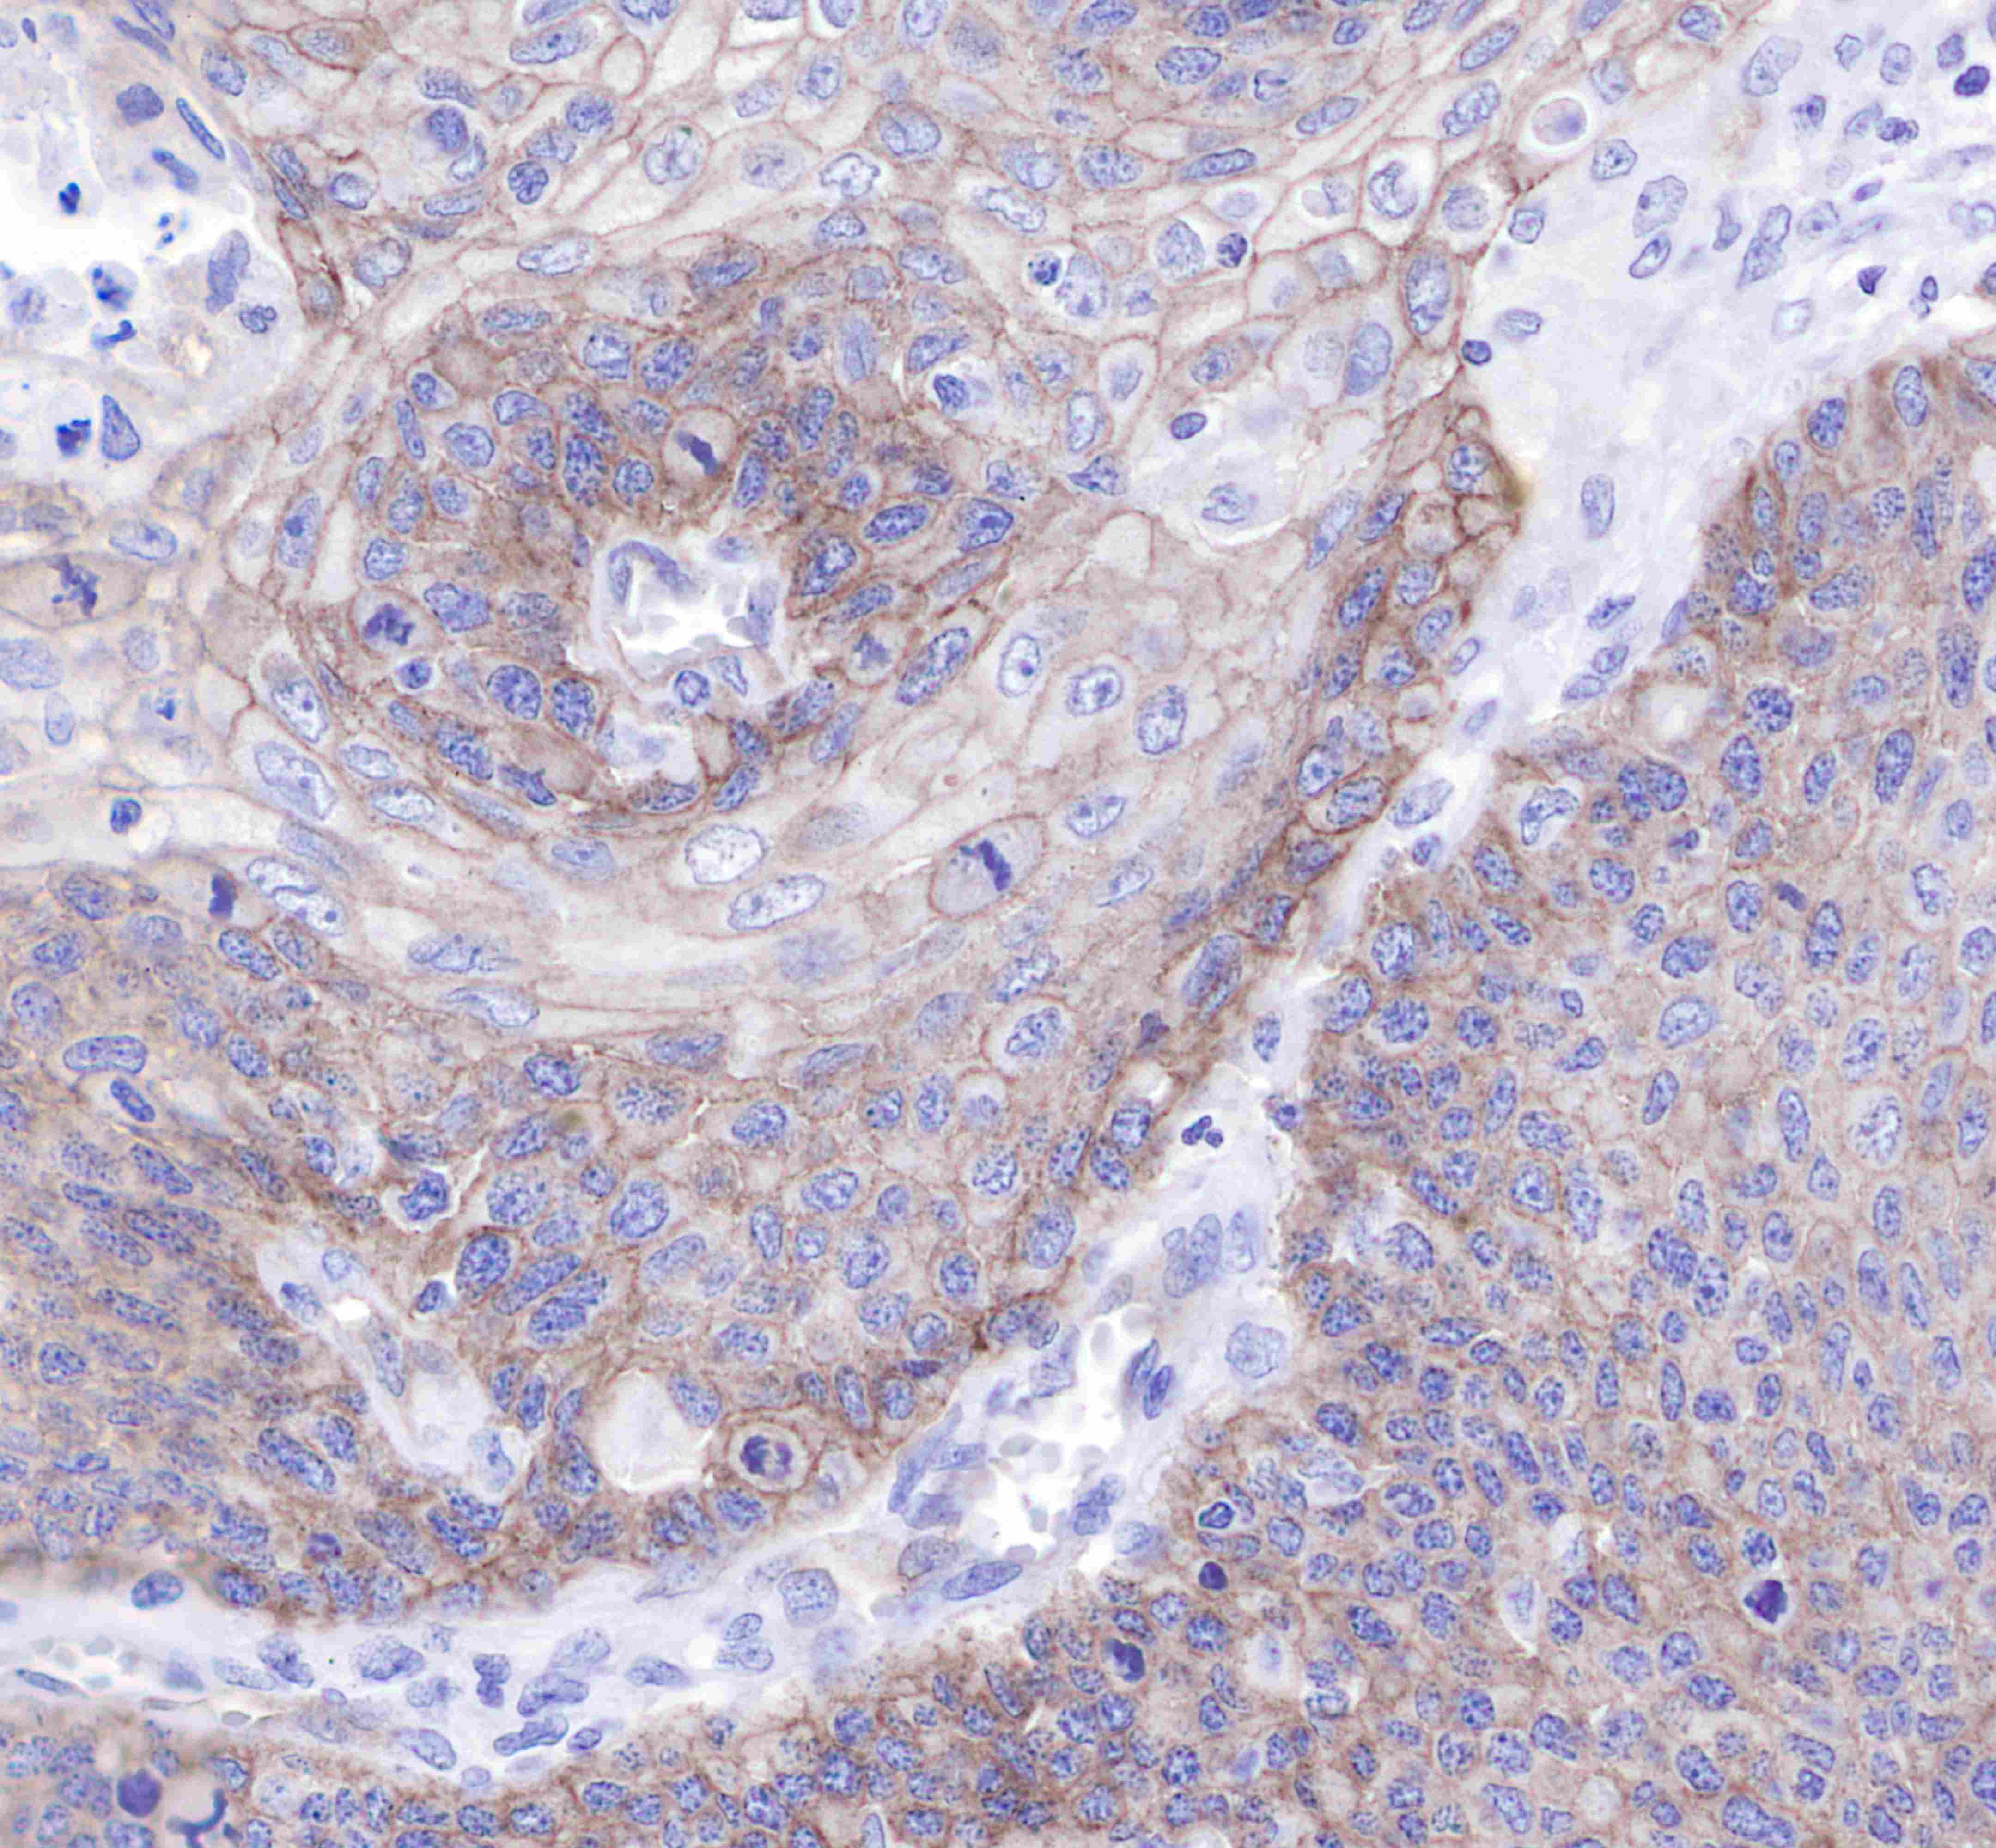

Product Specification
| Host |
Rabbit |
| Antigen |
c-Met |
| Synonyms |
HGF/SF receptor, Proto-oncogene c-Met, Scatter factor receptor (SF receptor), Tyrosine-protein kinase Met |
| Immunogen |
Synthetic Peptide |
| Location |
Cytoplasm, Membrane |
| Accession |
P08581 |
| Clone Number |
SDT-009-7 |
| Antibody Type |
Rabbit mAb |
| Isotype |
IgG |
| Application |
WB, IHC-P, ICC, ICFCM |
| Reactivity |
Hu |
| Purification |
Protein A |
| Research Area |
Signal Transduction |
| Concentration |
0.5mg/ml |
| Molecular Weight |
140kDa,170kDa |
| Conjugation |
Unconjugated |
| Physical Appearance |
Liquid |
| Storage Buffer |
PBS, 40% Glycerol, 0.05%BSA, 0.03% Proclin 300 |
| Stability & Storage |
12 months from date of receipt / reconstitution, -20 °C as supplied |
Dilution
| application |
dilution |
species |
| WB |
1:5000 |
|
| ICFCM |
1:500 |
|
| IHC-P |
1:250 |
|
| ICC |
1:500 |
|
Background
c-Met, also called tyrosine-protein kinase Met or hepatocyte growth factor receptor (HGFR), is a protein that in humans is encoded by the MET gene. The protein possesses tyrosine kinase activity. The primary single chain precursor protein is post-translationally cleaved to produce the alpha and beta subunits, which are disulfide linked to form the mature receptor. MET is a single pass tyrosine kinase receptor essential for embryonic development, organogenesis and wound healing. Hepatocyte growth factor/Scatter Factor (HGF/SF) and its splicing isoform (NK1, NK2) are the only known ligands of the MET receptor. MET is normally expressed by cells of epithelial origin, while expression of HGF/SF is restricted to cells of mesenchymal origin. When HGF/SF binds its cognate receptor MET it induces its dimerization through a not yet completely understood mechanism leading to its activation. Abnormal MET activation in cancer correlates with poor prognosis, where aberrantly active MET triggers tumor growth, formation of new blood vessels (angiogenesis) that supply the tumor with nutrients, and cancer spread to other organs (metastasis). MET is deregulated in many types of human malignancies, including cancers of kidney, liver, stomach, breast, and brain. Normally, only stem cells and progenitor cells express MET, which allows these cells to grow invasively in order to generate new tissues in an embryo or regenerate damaged tissues in an adult. However, cancer stem cells are thought to hijack the ability of normal stem cells to express MET, and thus become the cause of cancer persistence and spread to other sites in the body. Both the overexpression of Met/HGFR, as well as its autocrine activation by co-expression of its hepatocyte growth factor ligand, have been implicated in oncogenesis.